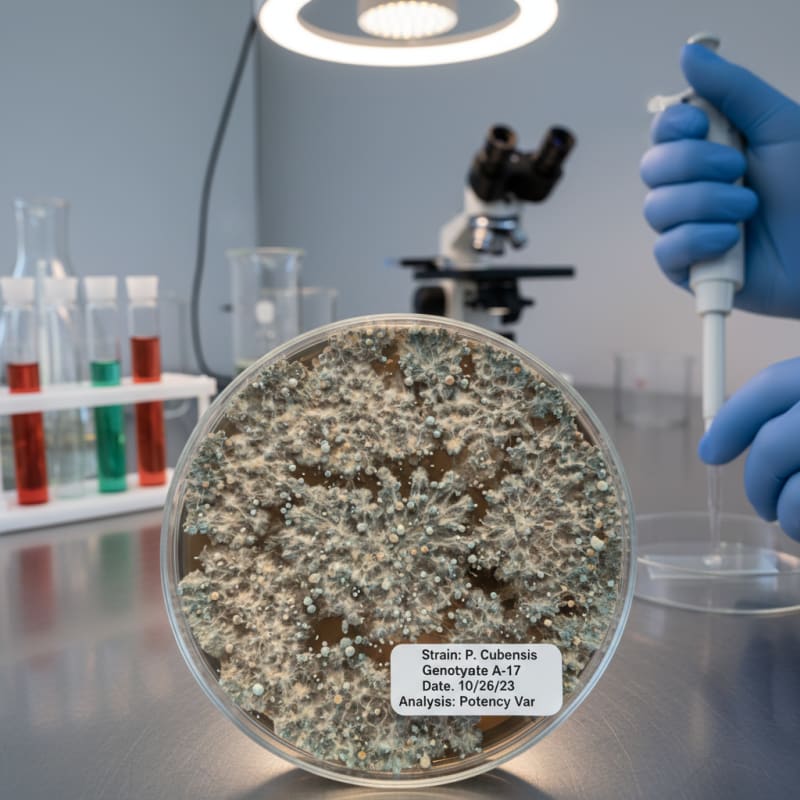
mushroom potency illustration 3

Why Mushroom Potency Varies
Quick Summary
Mushroom potency varies due to genetics, growing conditions, maturity at harvest, and storage. Different strains produce different concentrations of psilocybin. Improper storage can degrade compounds over time.

The potency of psilocybin mushrooms can vary widely even within the same species.
Several factors influence how much psilocybin and psilocin a mushroom contains.
Genetics
Different strains have different genetic profiles.
Some strains naturally produce higher concentrations of psilocybin. For more on specific strains, see the mushroom strains guide.
Growing Conditions
Environmental conditions such as temperature, humidity, and substrate can influence mushroom development.
These conditions may affect the concentration of active compounds.
Maturity at Harvest
The stage at which mushrooms are harvested can also affect potency.
Some mushrooms produce higher concentrations of compounds during certain stages of growth.
Storage
Improper storage can lead to degradation of psilocybin over time.
Exposure to heat, light, and moisture can reduce potency. Following proper storage practices helps preserve the original compound levels.
Understanding these factors helps explain why lab testing is used to measure actual compound concentrations rather than relying on visual appearance alone.
ShroomDash Editorial Team
Published 2026-03-08 · 2 min read · Education



